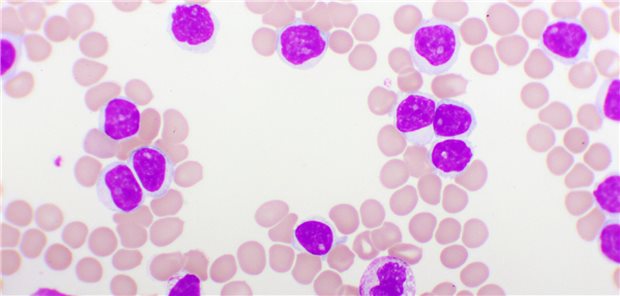
CLL: Langzeitdaten bestätigen Wirksamkeit von Ibrutinib plus Venetoclax Mikroskopieaufnahme eines Blutbild bei chronischer lymphatischer Leukämie (CLL).

Themenseite Lymphome/Leukämie
Themenseite - Lymphome/Leukämie
24.10.2025
|
Pflanzenheilkunde
Phytotherapie bei Krebs: Kräuter und Wurzeln mit Wechselwirkungspotenzial!
10.09.2025
|
Hinweise auch für andere Krebsarten
Statine könnten sich positiv auf die Prognose bei Prostatakrebs auswirken
26.08.2025
|
„Think before you ink!“
Dänische Zwillingsstudie deutet auf erhöhtes Krebsrisiko bei Tätowierten hin
Podcasts
„ÄrzteTag“-Podcast
Wie haben Sie den Düsseldorf-Patienten von HIV geheilt, Dr. Jensen?
Meinung